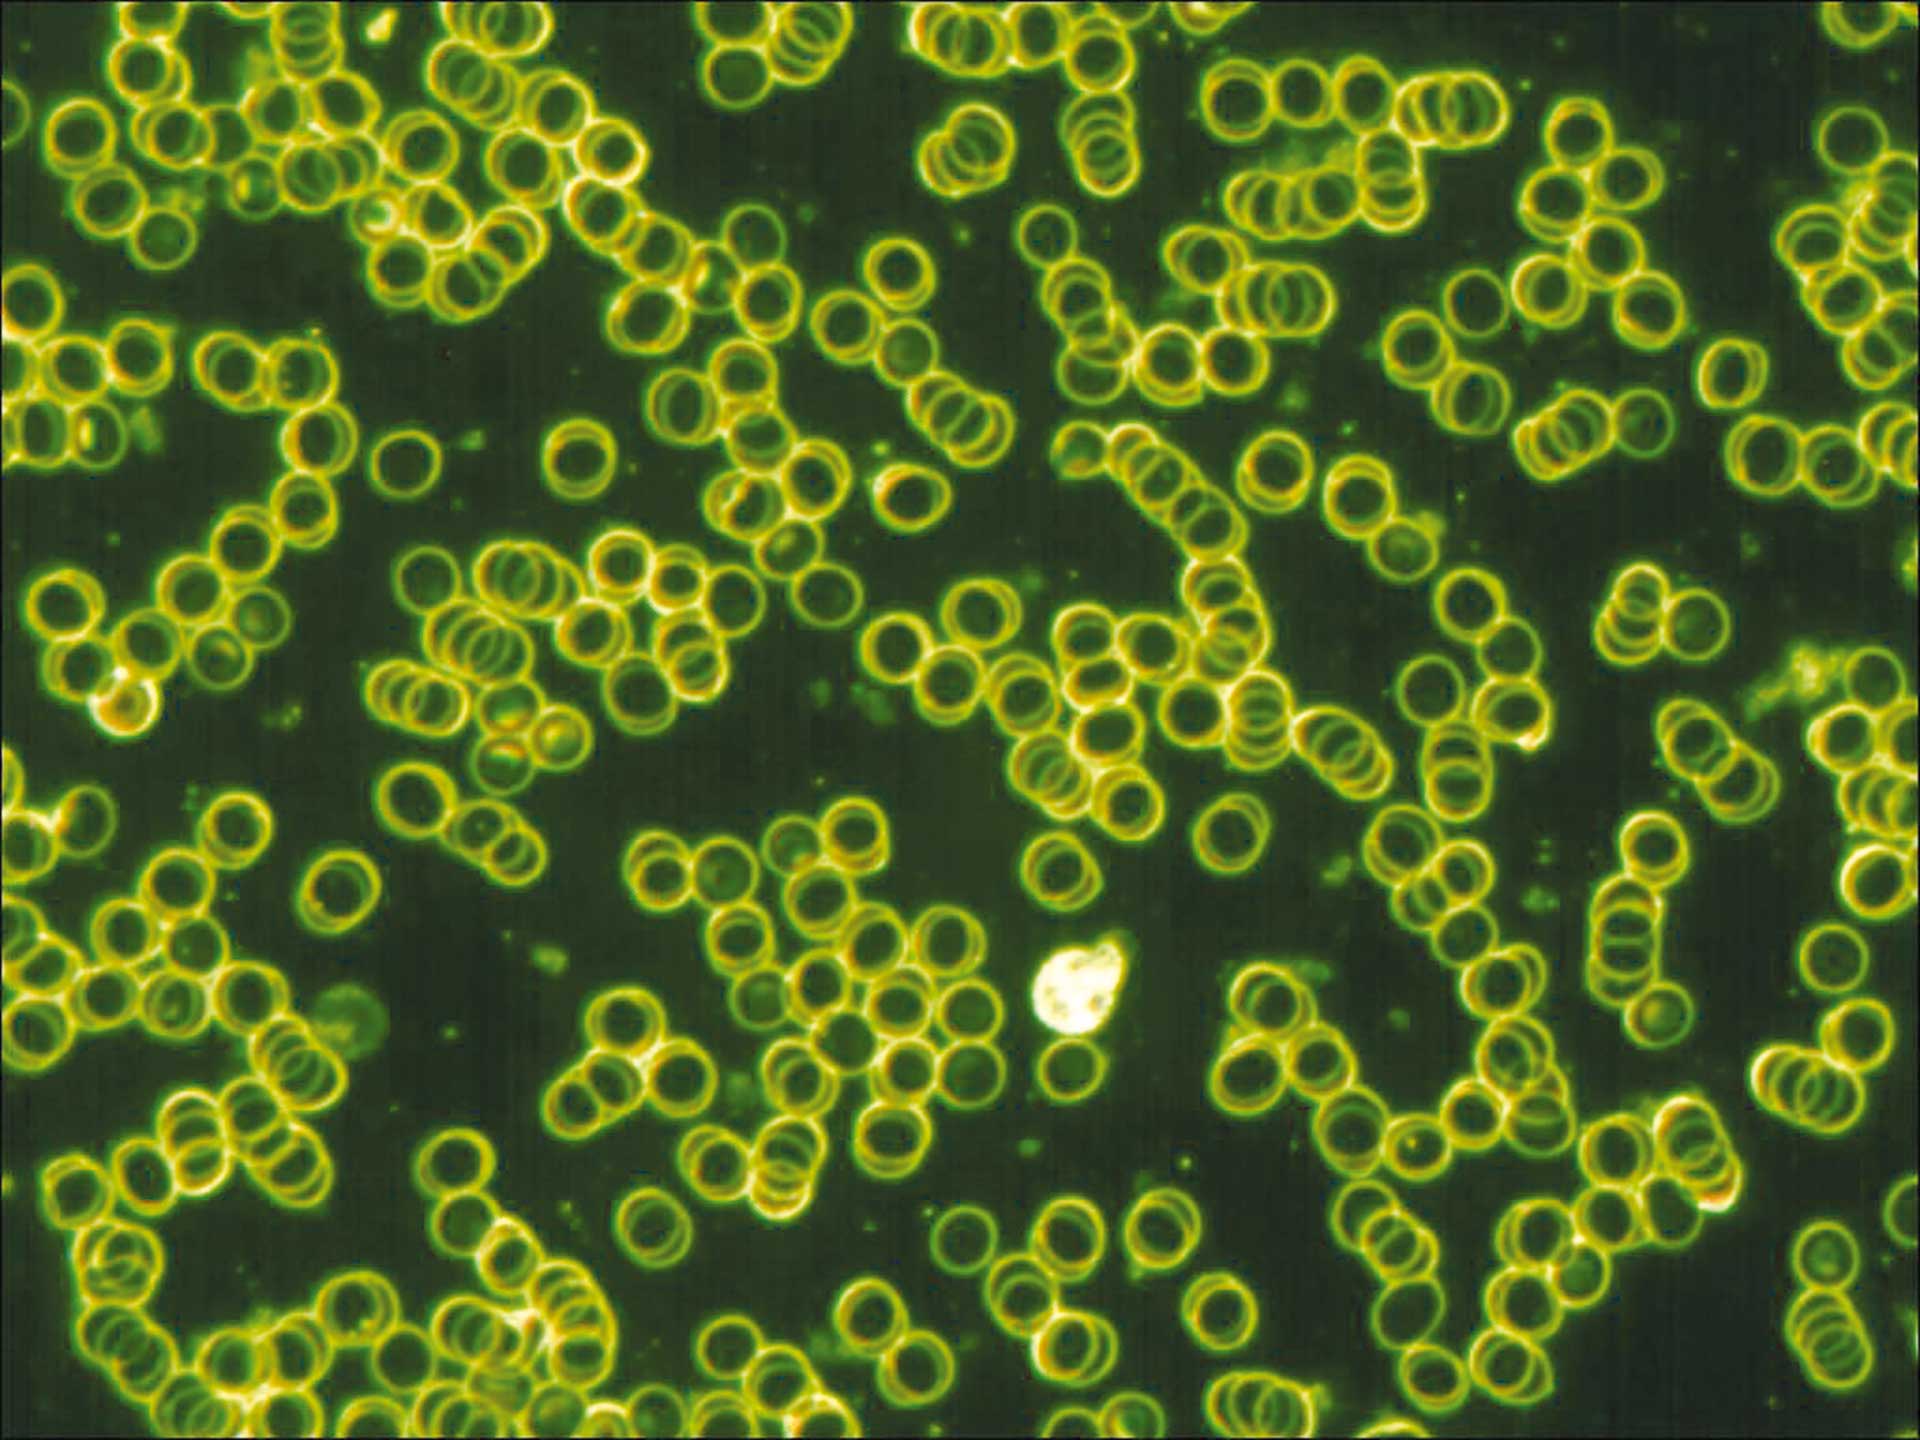
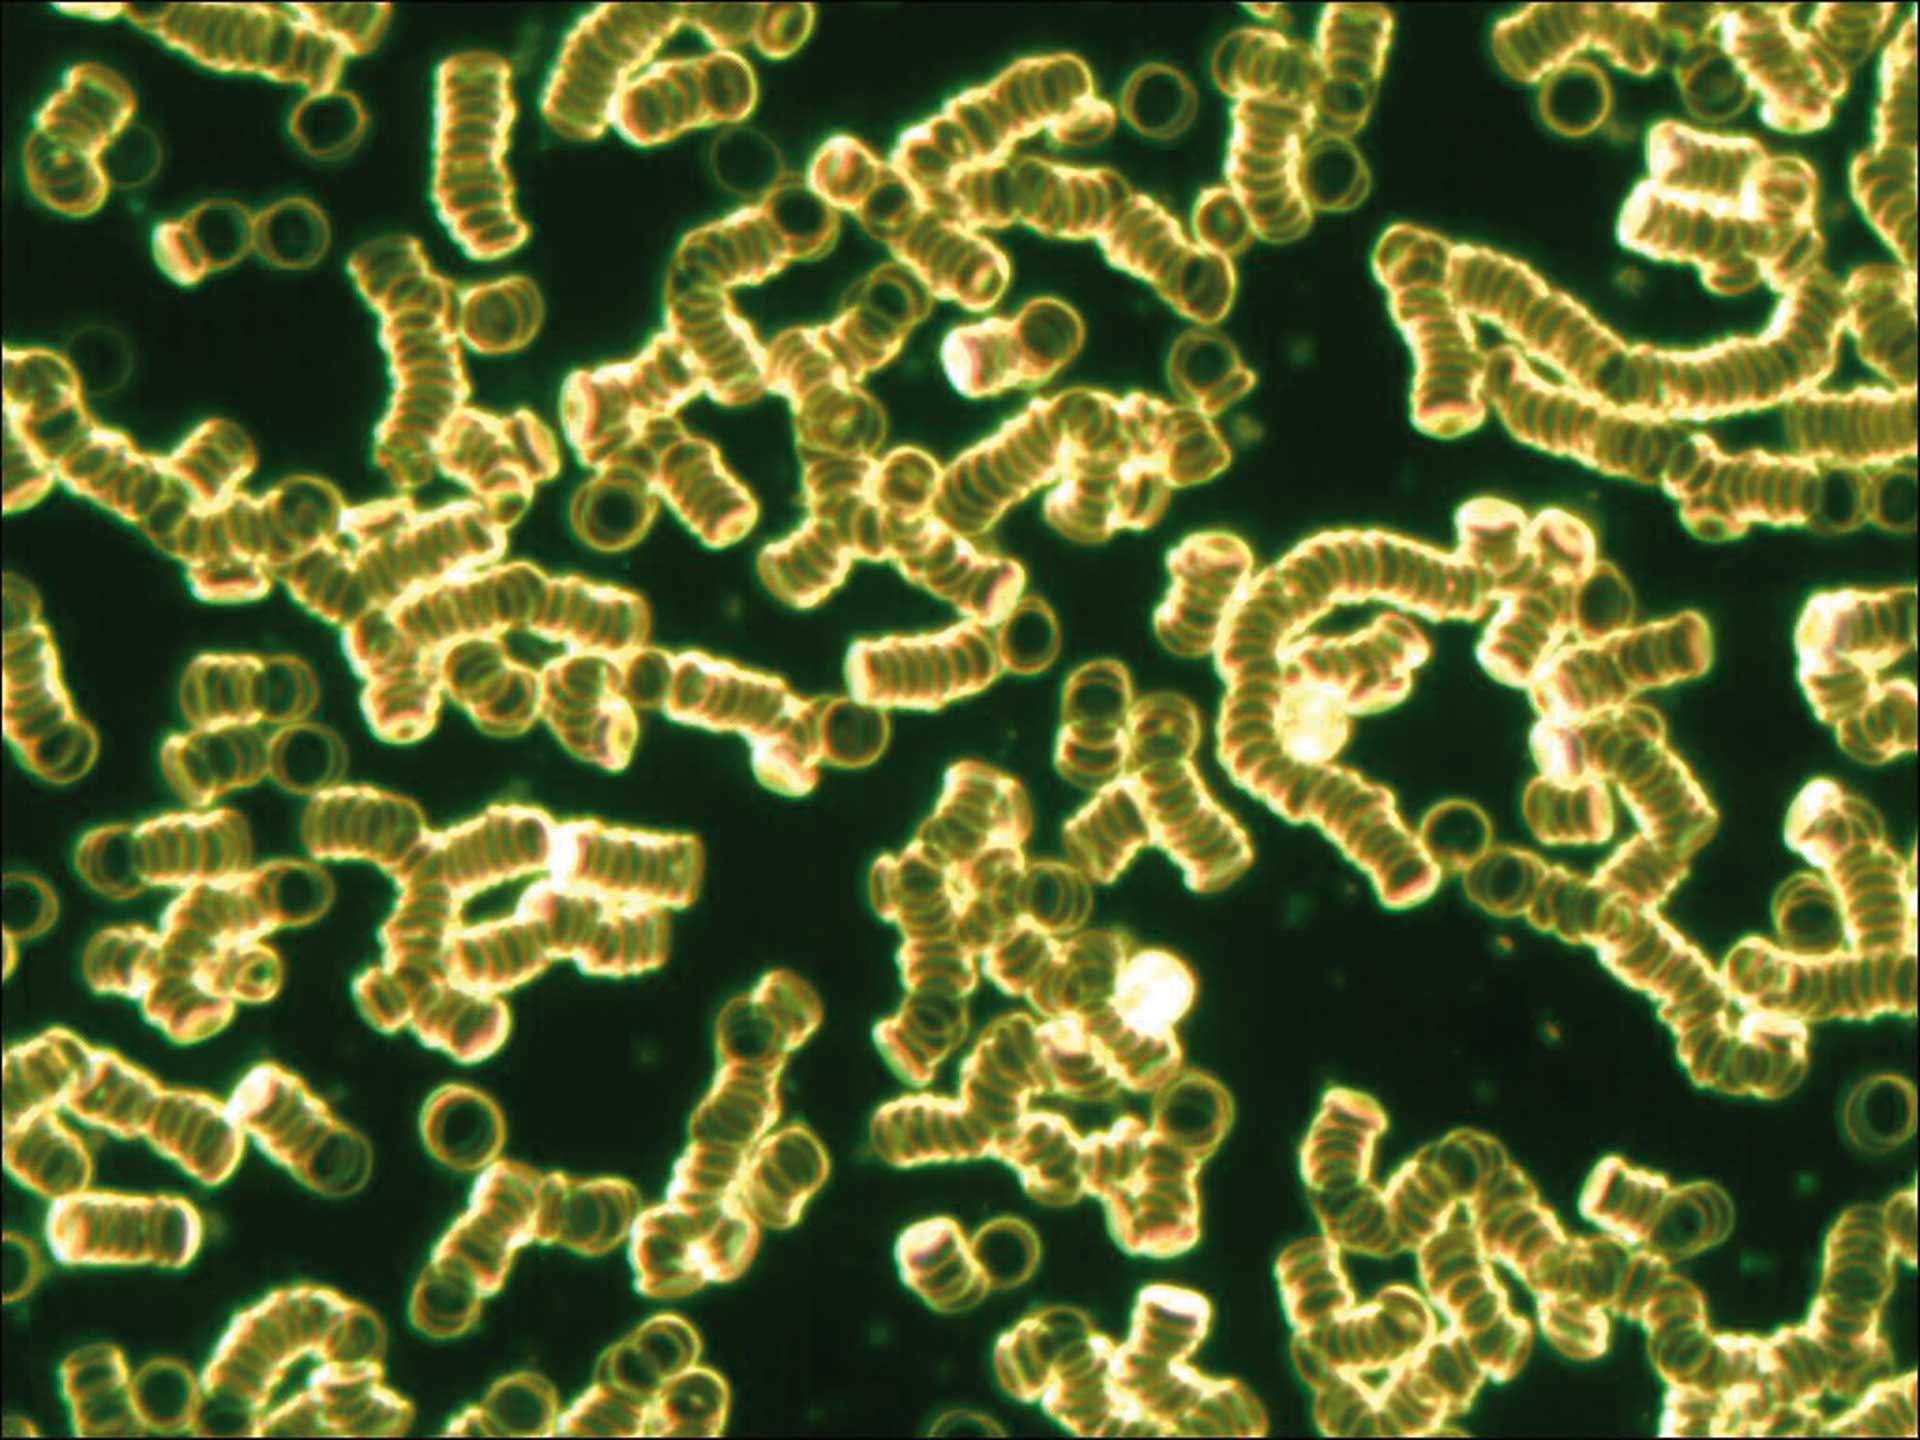
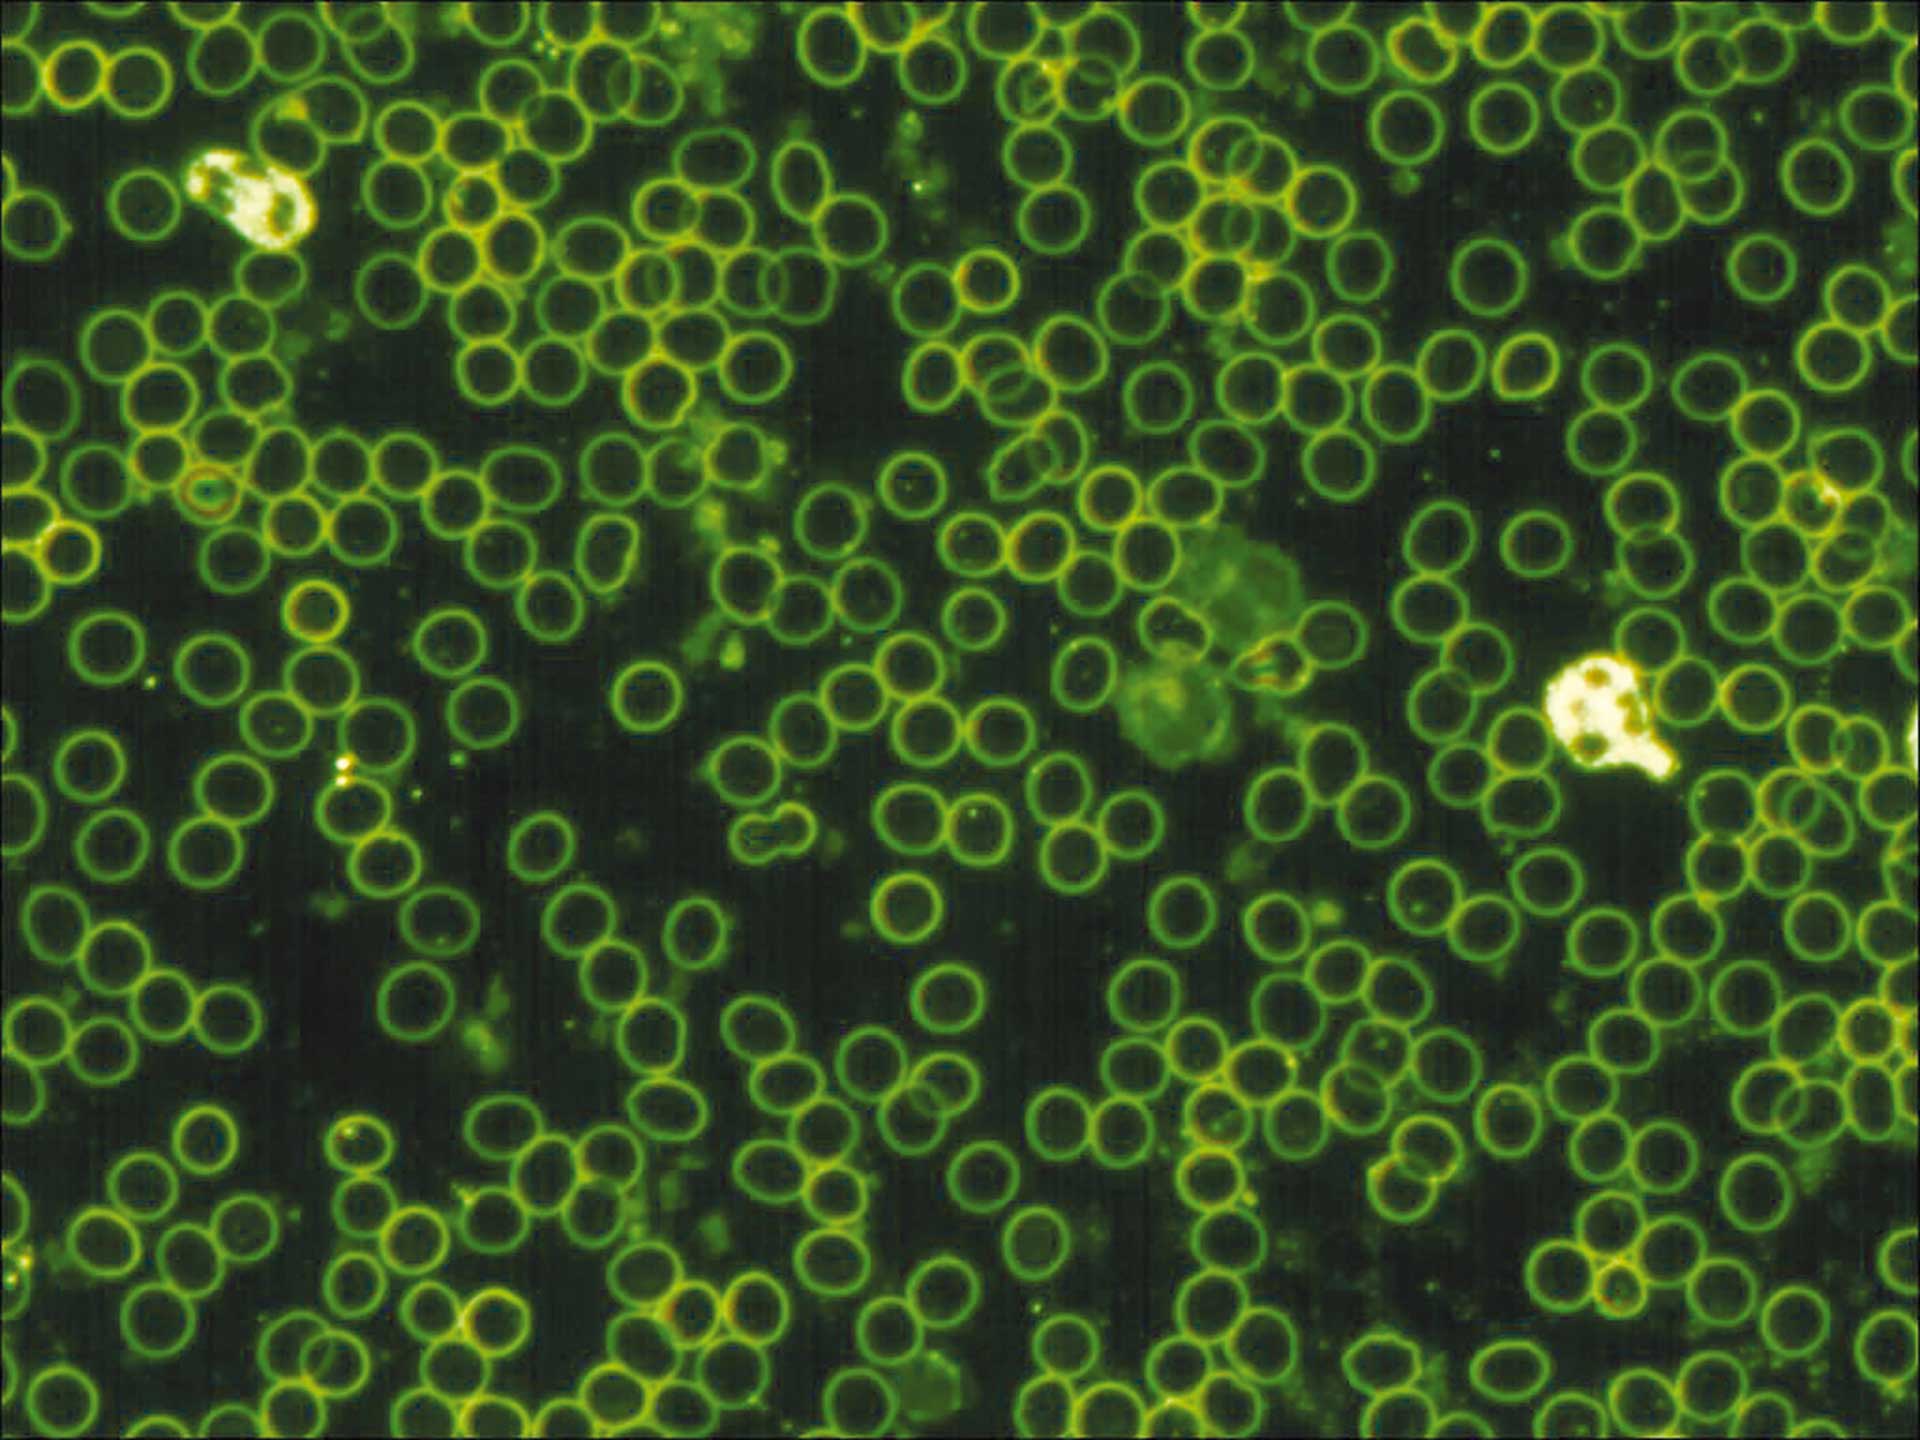
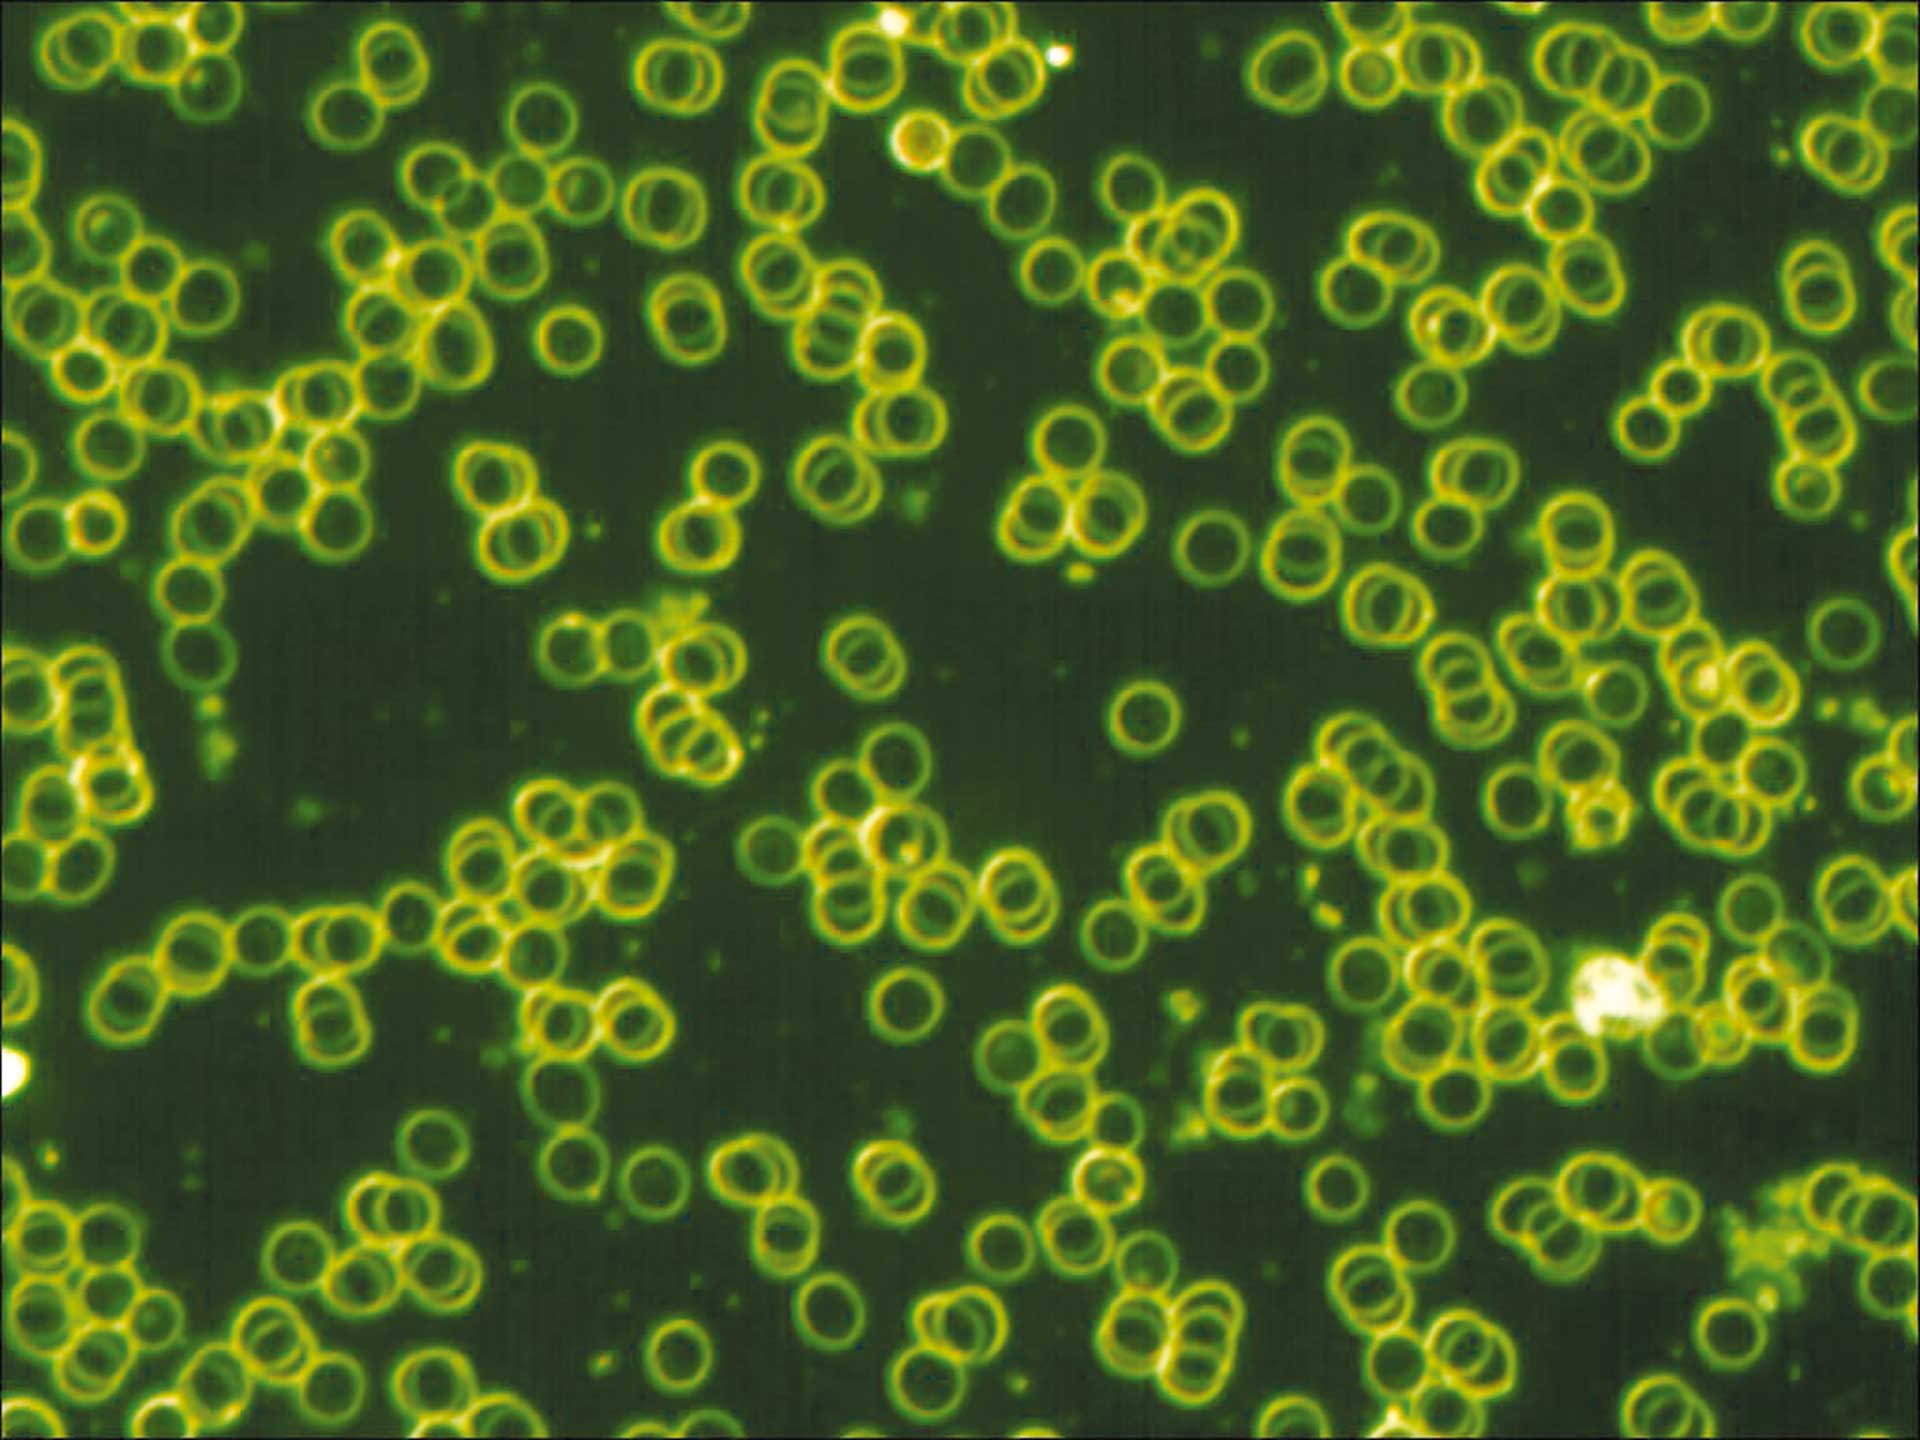

Die gesundheitlichen und ökologischen Probleme, die durch elektromagnetische Frequenzen (EMF) von technischen Quellen wie WLAN, Handy, Mobilfunkmasten, Smartmeter, Radar und viele andere erzeugt werden, bereiten vielen Menschen Sorgen. Mit dem neuesten Mobilfunkstandard 5G kommt nun eine weitere Dimension der EMF-Belastung auf uns zu, einerseits wegen der besonders energiereichen hochfrequenten Strahlung dieser Technologie, andererseits wegen der Bündelung von 5G-Signalen. Letzteres ist als sogenanntes Beam-Forming bekannt. Es ist für die höhere Datenübertragungsrate der Signale notwendig, bedeutet aber auch eine höhere Konzentration der EMF und damit stärkere Belastung als bei der diffusen Strahlung der Vorgänger-Standards. Außerdem ist es nicht so, dass mit 5G die alten Standards einfach verschwinden, sondern diese bleiben teilweise weiterhin aktiv, sodass es in der Summe zu einer höheren EMF-Belastung kommt.Â
Goldstandard der Wirksamkeit
Seit Mitte der 1990er Jahre boomt ein wachsender Markt an Produkten, die mit der guten Absicht hergestellt und angeboten werden, Elektrosmog zu neutralisieren. Ich untersuche solche Produkte seit 1994 und erlebe dabei, dass die Hersteller sich zumeist redliche Mühe geben, gute Produkte anzubieten. Doch in der Praxis zeigt sich wiederholt, dass der Wirksamkeitsnachweis, trotz mancher positiver Messungen, an einem sehr realen Test scheitert: die subjektive Erfahrung von Menschen, die hochsensibel für Elektrosmog sind. Ich habe im Laufe der Jahre Hunderte von Menschen kennengelernt, die jeweils Tausende von Euro für verschiedene Produkte ausgegeben haben und deren diffuse Symptome des Unwohlseins durch Handy, WLAN, Aufenthalt in Großstädten, Zug- oder Autofahrten sich nicht gebessert haben.Â
Wenn diese Menschen, deren Körper einfach ein sensibleres Instrument für die Auswirkungen von EMFs ist, keine Besserung erfahren, gehe ich nicht davon aus, dass andere Menschen wirklich von den entsprechenden Produkten profitieren. Nur weil die akute Sensitivität bei den Nicht-Hochsensiblen auf einen gesundheitsschädlichen Faktor weniger stark ausgeprägt ist, heißt es nicht, dass er nicht wirkt. Der Kettenraucher, der auf Zigarettenrauch nicht akut sensibel reagiert, ist ja auch nicht vor dessen Langzeitfolgen geschützt.Â
Neurasthenie = Elektrokrankheit
Hochsensibilität für elektromagnetische Felder wurde bereits im
19. Jahrhundert thematisiert, als der Begriff Elektrokrankheit synonym mit Neurasthenie verwendet wurde. Diese war 1869 von dem US-amerikanischen Neurologen George Miller Beard als Nervenschwäche in die Medizin eingeführt worden. Damals fiel auf, dass besonders Mitarbeiter von Telegrafie-Stationen von den Symptomen Müdigkeit, Konzentrationsstörungen, Schlafstörungen, Gereiztheit, Überempfindlichkeit – allesamt Störungen des Nervensystems – betroffen waren.Â
Was wir heute Burn-out nennen, gab es auch damals schon und weil Elektrizität neu und noch nicht überall gegenwärtig war, fiel dieser Zusammenhang deutlich auf. Elektrosmog-Hochsensible sind keineswegs schwer krank, meistens sind junge und mittelalte Erwachsene davon betroffen, ebenso schwangere Frauen. Aus einem Verständnis von vernetzter Lebensenergie ist das auch logisch: Wenn das eigene Energiefeld gut angebunden ist an die Atmosphäre und die Erde, werden Störungen in diesem Lebensumfeld stärker registriert. Hochbetagte Menschen, bei denen sich die Lebenskraft langsam zurückzieht und das persönliche Energiefeld kleiner wird, werden solche Störungen durch EMF weniger bemerken.Â
Gefahr von Langzeitfolgen
Wenn wir eine wirklich effektive Lösung für das Problem Elektrosmog anstreben, müssen sich die Wirkungen auch an den Menschen beweisen, die hochsensibel für EMF sind. Ansonsten kann es sein, dass manche guten Effekte von EMF-Schutzprodukten einfach dadurch entstehen, dass sie einen direkten positiven Effekt auf den Körper der Anwender haben, ohne die EMFs, die auf sie wirken, tatsächlich zu neutralisieren. Dies würde dann allerdings Langzeitfolgen begünstigen.Â
Die Nutzung feinstofflicher Energien und Ordnungsprinzipien zur Anregung von körpereigenen Selbstheilungskräften oder zur Belebung von Wasser ist ein Gebiet, zu dem viel Wissen in der Naturheilkunde und ganzheitlichen Wissenschaft vorhanden ist. Viele Hersteller von EMF-Schutzprodukten übertragen nun diese Wirkungsprinzipien auf den Versuch, EMFs zu neutralisieren.Â
Der fundamentale Denkfehler
Und hierin besteht ein fundamentaler Denkfehler. Während jedes Wassermolekül auf Erden schon mal artesisches Quellwasser war und deshalb in sich die Erinnerung an einen energetisch optimalen Zustand trägt, hat ein WLAN-Router keine Erinnerung an einen ausgewogenen energetischen Zustand in sich. In gleicher Weise tragen unsere Körper starke Selbstheilungskräfte in sich, die durch einen „Hauch von Information“, wie bei einem gut gewählten homöopathischen Mittel, angeregt werden können; dagegen kennt Handystrahlung keinerlei eigene Selbstregulation und besitzt auch keinerlei Streben nach einer natürlichen Ordnung. Das aber bedeutet: Technisch erzeugte energetische Probleme lassen sich nicht auf die gleiche Weise beheben wie energetische Blockaden oder Stagnationen in lebendigen Organismen und natürlichen Substanzen. Wenn ein disharmonisches, lebendiges Energiesystem auf harmonische Energie trifft, kann durch den sogenannten Entrainment-Effekt das disharmonische Energiesystem wieder in Harmonie gebracht werden. Ein nicht-lebendiges Energiefeld technischer Herkunft kann dagegen einen solchen Synchronisierungseffekt nicht durchlaufen, weil es dafür schlicht keine Veranlagung besitzt.Â
Alle organisierten Systeme im uns bekannten Universum, vom Atom bis zu den Galaxien, weisen eine Torus-Struktur auf. Auch die energetische Anatomie des Menschen wird in traditionellen Darstellungen wie in den Yoga-Lehren des kashmirischen Shaivismus und im Taoismus als Torus beschrieben. In der Symmetrieachse eines Torus gibt es einen Mittelpunkt, der im menschlichen Energiesystem mit dem Herzzentrum zusammenfällt. Interessanterweise zeigen Menschen aller Kulturen auf ihr Herz, wenn sie auf sich selbst zeigen, niemand weist dabei auf seinen Kopf oder Ellbogen.